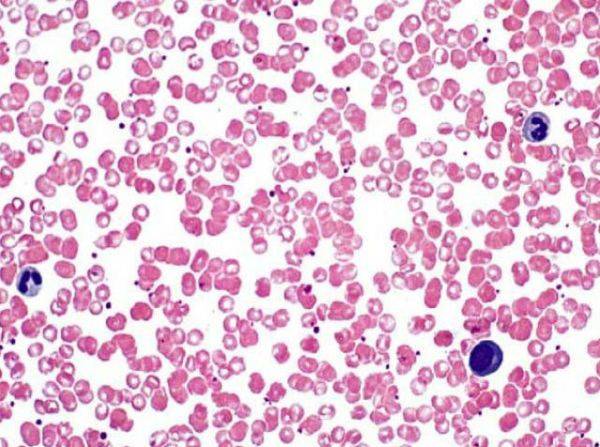

Тромбоциты
Основная роль тромбоцитов
Тромбоциты — это не полноценные клетки, а небольшие дискообразные клеточные фрагменты. Они намного меньше красных или белых кровяных клеток, обычно их диаметр составляет от 2 до 4 микрометров. У зрелых тромбоцитов нет ядра, но они содержат другие органеллы и клеточные структуры. Тромбоциты содержат гранулы, наполненные различными веществами, включая ферменты, факторы свертывания крови и химические вещества, участвующие в восстановлении кровеносных сосудов.
Тромбоциты играют решающую роль в гемостазе, процессе предотвращения и остановки кровотечения. Он включает в себя четыре основных этапа:
- Вазоконстрикция: сужение кровеносных сосудов для уменьшения кровотока.
- Первичный гемостаз: образование временной «тромбоцитарной пробки» в месте повреждения кровеносного сосуда. Тромбоциты прилипают к обнаженному коллагену и другим поверхностям в месте повреждения.
- Вторичный гемостаз: активация каскада свертывания крови, приводящая к образованию стабильного тромба.
- Ретракция сгустка: после образования сгустка крови тромбоциты сокращаются, стягивая разорванные участки кровеносного сосуда вместе и уменьшая размер сгустка.
Тромбоциты выделяют факторы роста, которые стимулируют процесс заживления и способствуют восстановлению тканей. Эти клетки также играют роль в иммунном ответе, взаимодействуя с лейкоцитами и выделяя вещества, модулирующие воспаление. Тромбоциты выделяют факторы роста, которые способствуют образованию новых кровеносных сосудов — процесс, известный как ангиогенез. Они также взаимодействуют с различными факторами свертывания крови, способствуя образованию и стабилизации сгустков крови. Тромбоциты способствуют начальным стадиям заживления ран, предотвращая чрезмерное кровотечение и способствуя восстановлению поврежденных кровеносных сосудов.
Тромбоциты: норма и отклонения
Норма по количеству тромбоцитов: от 150 000 до 450 000 тромбоцитов на микролитр (мкл) крови.
Тромбоцитоз – повышение количества тромбоцитов. Возможные причины:
- Воспалительные состояния
- Хронические инфекции
- Железодефицитная анемия
- Некоторые виды рака
- Постспленэктомия (удаление селезенки)
Тромбоцитопения – снижение количества тромбоцитов. Возможные причины:
- Иммунная тромбоцитопения (ИТП)
- Вирусные инфекции (например, ВИЧ, гепатит)
- Лекарства (например, некоторые антибиотики, химиотерапевтические препараты)
- Заболевания костного мозга
- Аутоиммунные заболевания
Тромбоцитемия – стойкое повышение количества тромбоцитов. Возможные причины:
- Эссенциальная тромбоцитемия (заболевание костного мозга)
- Хронический миелолейкоз (ХМЛ)
- Истинная полицитемия
Аномальная функция или структура тромбоцитов. Возможные причины:
- Болезнь фон Виллебранда
- Нарушения функции тромбоцитов
- Наследственные заболевания, влияющие на функцию тромбоцитов
Нарушения агрегации тромбоцитов – нарушение способности тромбоцитов слипаться и образовывать тромбы. Возможные причины:
- Аспирин или другие антитромбоцитарные препараты
- Наследственные нарушения функции тромбоцитов
- Приобретенные нарушения, влияющие на функцию тромбоцитов
Заболевания, связанные с нарушением форменных элементов крови
Различные заболевания и состояния могут поражать эритроциты, тромбоциты и лейкоциты, например:
- Анемия – это состояние, характеризующееся уменьшением количества эритроцитов или уменьшением количества гемоглобина в крови. Причины: дефицит железа, дефицит витамина B12, дефицит фолиевой кислоты, хронические заболевания, гемолитические анемии и наследственные заболевания, такие как серповидно-клеточная анемия.
- Полицитемия – это увеличение количества эритроцитов. Причины: первичная истинная полицитемия (заболевание костного мозга), вторичная полицитемия, вызванная такими состояниями, как хроническая гипоксия или некоторые опухоли.
- Лейкемия — это рак крови и костного мозга, характеризующийся перепроизводством аномальных лейкоцитов. Причины: генетические мутации, воздействие определенных химических веществ или радиации.
- Лимфома — это рак, поражающий лимфатическую систему, включая лимфоциты (разновидность лейкоцитов). Причины: генетические факторы, вирусные инфекции (например, вирус Эпштейна-Барра), иммунодефицитные состояния.
- Тромбоцитопения – это уменьшение количества тромбоцитов в крови. Причины: иммунная тромбоцитопеническая пурпура (ИТП), лекарственные препараты, вирусные инфекции, заболевания костного мозга.
- Тромбоцитоз – это увеличение количества тромбоцитов. Причины: реактивный тромбоцитоз вследствие воспаления или инфекции, миелопролиферативные заболевания.
- Гемофилия — это генетическое заболевание, которое влияет на способность крови правильно свертываться. Причины: Наследственные генетические мутации, влияющие на факторы свертывания крови.
- Миелодиспластические синдромы (МДС) – группа заболеваний, характеризующихся неэффективной выработкой клеток крови в костном мозге. Причины: генетические мутации, воздействие определенных токсинов или химиотерапия.
- Апластическая анемия — это состояние, при котором костный мозг не может производить достаточное количество клеток крови. Причины: идиопатические (неизвестная причина), воздействие некоторых лекарств или токсинов, вирусные инфекции.
- Серповидноклеточная анемия — это генетическое заболевание, поражающее эритроциты, в результате чего они становятся жесткими и приобретают форму полумесяца. Причины: Наследственные генетические мутации.
Это всего лишь несколько примеров. На форменные элементы крови могут влиять многие другие состояния. Нарушения, влияющие на клетки крови, могут быть результатом генетических факторов, инфекции, аутоиммунных реакций, воздействия токсинов или злокачественных новообразований. Диагностика и лечение часто включают лабораторные тесты, визуализирующие исследования и специализированные процедуры для оценки количества, морфологии и функции клеток крови.
Определение
Лейкоцитами
называют один из видов кровяных телец организма человека и животных. Из-за отсутствия окраски они называются белыми кровяными клетками. Помимо этого, характерной особенностью лейкоцитов является наличие ядра. В норме у человека около 4х10 9 – 8,5х10 9 /л, и их количество все время варьируется в этих пределах в зависимости от времени суток и состояния самого организма. Повышение уровня лейкоцитов наблюдается после приема пищи, физической или эмоциональной нагрузки, в вечерние часы, а также вследствие развития воспалительных и опухолевидных процессов. В организме лейкоциты выполняют защитную функцию, играя важную роль в процессах специфической и неспецифической защиты. Лейкоциты проходят через стенки капилляров и проникают в ткани, где происходит поглощение и переваривание чужеродных частиц. Этот процесс получил название ”фагоцитоз”.
Эритроциты
– высокоспециализированные клетки, и их основная функция – перенос кислорода к тканям организма и осуществление газообмена. Эта функция достигается как раз благодаря гемоглобину. В состав эритроцитов большинства животных входит ядро и прочие органоиды, у млекопитающих зрелые эритроциты лишены ядер, органоидов и мембраны. По форме они представляют собой двояковогнутый диск, содержащий в себе гемоглобин, что и обуславливает их красный цвет. Тем не менее, полностью красными являются только зрелые эритроциты, на более ранних стадиях, пока клетки еще не успевают запастись гемоглобином, они имеют синюю окраску. Эритроциты составляют в диаметре приблизительно 7 мкм, но они способны претерпевать значительные деформации, восстанавливаясь в исходное состояние. В норме количество эритроцитов у мужчин составляет — 4,5·10 12 /л-5,5·10 12 /л, у женщин — 3,7·10 12 /л-4,7·10 12 /л.
Итак, мы выяснили, что лейкоцитами принято называть белые кровяные клетки, а эритроцитами – красные. Лейкоциты отвечают за защиту организма от чужеродных антигенов, эритроциты осуществляют транспортировку кислорода и углекислого газа.
Особенности эритроцитов
Эритроциты или красные кровяные тельца присутствуют в крови всех позвоночных животных и человека. Они насыщаются кислородом в легких, после чего транспортируют данное вещество по всему организму.
Строение и свойства
Эритроциты в современном понимании – это красные клетки крови в виде маленьких эластичных структур дисковидной двояковогнутой формы, имеющих диаметр от 7 до 10 микрометров.
Особая эластичность и размеры эритроцитов способствуют активному движению по капиллярам, а форма повышает площадь рабочей поверхности и облегчает газовый обмен.
В эритроцитах отсутствует клеточная ядра и большинство известных органелл, но есть высокое содержание гемоглобина, который в свою очередь и дает характерный красный оттенок вышеописанному компоненту.
Красные тельца формируются в костном мозге, вплоть до 2,5 миллионов элементов ежесекундно (подробнее про скорость оседания эритроцитов вы узнаете здесь). После синтеза они циркулирует в крови до 120 дней и поглощаются макрофагами.
Функциональные характеристики
Красные кровяные тельца представляют собой высокоспециализированные клетки, основной функцией которых выступает процесс перенос кислорода из легких к мягким тканям, а также транспорт оксида углерода по обратной связи в противоположном направлении. Данный процесс проводится с активным участием гемоглобина.
Прямое направление транспорта кислорода обеспечивается присутствием промежуточных продуктов гликолиза, способствующих высвобождению кислорода уже в тканях. Обратный процесс происходит с участием карбоангидразы, которая содержится в цитоплазме и позволяет катализировать реакции образования бикарбонатов из углекислого газа и воды.
Лейкоциты (белые клетки крови)
Белые кровяные тельца или белые клетки крови, которые также называют ами, составляют вместе с тромбоцитами у здоровых людей лишь 1 % всех клеток крови. Нормальным считается уровень от 5.000 до 8.000 лейкоцитов в микролитре крови.
Лейкоциты отвечают за имунную защиту организма. Они распознают „чужаков“, например, , ы или грибы, и обезвреживают их. Если есть , количество лейкоцитов может сильно вырасти за короткое время. Благодаря этому организм быстро начинает бороться с возбудителями болезни.
Лейкоциты делят на разные группы в зависимости от их внешнего вида, от места, в котором они выросли, и от того, как именно они работают. Самую большую группу (от 60 до 70 %) составляют так называемые ы; от 20 до 30 % – ы и от 2 до 6 % – ы („клетки-пожиратели“).
Эти три вида клеток по-разному борются с возбудителями болезней, одновременно дополняя работу друг друга. Только благодаря тому, что они работают согласованно, организм обеспечивается оптимальной защитой от инфекций. Если количество белых клеток крови снижается, или они не могут работать нормально, например, при лейкозе, то защита организма от „чужаков“ (бактерий, вирусов, грибов) больше не может быть эффективной. Тогда организм начинает подхватывать разные инфекции.
Общее количество лейкоцитов измеряется в анализе крови . Характеристики различных типов белых кровяных клеток и их процентуальное соотношение могут исследоваться в так называемом дифференциальном анализе крови ().
Гранулоциты
Гранулоциты отвечают прежде всего за защиту организма от бактерий . Также они защищают от ов, грибов и паразитов (например, глистов). А называются они так потому, что в их клеточой жидкости есть зёрнышки (гранулы). В том месте, где появляется , они моментально накапливаются в большом количестве и становятся „первым эшелоном“, который отражает атаку возбудителей болезни.
Гранулоциты являются так называемыми фагоцитами. Они захватывают проникшего в организм противника и перевариваюи его (фагоцитоз). Таким же образом они очищают организм от мёртвых клеток. Кроме того, гранулоциты отвечают за работу с аллергическими и воспалительными реакциями, и с образованием гноя.
Уровень гранулоцитов в крови имеет в лечении онкологических болезней очень важное значение. Если во время лечения их количество становится меньше, чем 500 – 1.000 в 1 микролитре крови, то, как правило, очень сильно возрастает опасность инфекционных заражений даже от таких возбудителей, которые обычно вообще не опасны для здорового человека
Лимфоциты
Лимфоциты – это белые клетки крови, 70 % которых находится в тканях лимфатической системы. К таким тканям относятся, например, , селезёнка, глоточные миндалины (гланды) и .
Группы лимфоузлов находятся под челюстями, в подмышечных впадинах, на затылке, в области паха и в нижней части живота. Селезёнка – это орган, который находится слева в верхней части живота под рёбрами; вилочковая железа – небольшой орган за грудиной. Кроме того, лимфоциты находятся в лимфе. Лимфа – это бесцветная водянистая жидкость в лимфатических сосудах. Она, как и кровь, охватывает своей разветвлённой весь организм
Лимфоциты играют главную защитную роль в иммунной системе, так как они способны целенаправленно распознавать и уничтожать возбудителей болезней. Например, они играют важную роль при ной инфекции. Лимфоциты „организовывают“ работу ов, производя в организме так называемые . Атитела – это маленькие белковые молекулы, которые прицепляются к возбудителям болезни и таким образом помечают их как „врагов“ для фагоцитов.
Лимфоциты распознают и уничтожают клетки организма, поражённые вирусом, а также раковые клетки, и запоминают тех возбудителей болезни, с которыми они уже контактировали. Специалисты различают ы и ы, которые отличаются по своим иммунологическим характеристикам, а также выделяют некоторые другие, более редкие подгруппы лимфоцитов.
Моноциты
Моноциты – это клетки крови, которые уходят в ткани и там начинают работать как „крупные фагоциты“ (макрофаги), поглощая возбудителей болезней, инородные тела и умершие клетки, и зачищая от них организм. Кроме того часть поглощённых и переваренных организмов они презентируют на своей поверхности и таким образом активируют лимфоциты на иммунную защиту.
Компоненты внутренней среды
Любой организм — одноклеточный или многоклеточный — нуждается в определённых условиях существования. Эти условия обеспечивает организмам та среда, к которой они приспособились в ходе эволюционного развития.
Первые живые образования возникли в водах Мирового океана, и средой обитания для них служила морская вода. По мере усложнения живых организмов часть их клеток изолировалась от внешней среды. Так часть среды обитания оказалась внутри организма, что позволило многим организмам покинуть водную среду и начать жить на суше. Содержание солей во внутренней среде организма и в морской воде примерно одинаковое.
Внутренней средой для клеток и органов человека служат кровь, лимфа и тканевая жидкость.
Эритроциты
Эритроциты называются красными кровяными тельцами. Это самая многочисленная группа клеток. Они переносят кислород от органов дыхания к тканям и принимают участие в транспортировке углекислого газа от тканей к легким.
Место образование эритроцитов – красный костный мозг. Живут они 120 дней и разрушаются в селезенке и печени.
Образуются из клеток-предшественниц – эритробластов, которые перед превращением в эритроцит проходят разные стадии развития и несколько раз делятся. Таким образом, из эритробласта образуется до 64 красных кровяных клеток.
Эритроциты лишены ядра и по форме напоминают вогнутый с двух сторон диск, диаметр которого в среднем составляет около 7-7,5 мкм, а толщина по краям – 2,5 мкм. Такая форма способствует увеличению пластичности, необходимой для прохождения по мелким сосудам, и площади поверхности для диффузии газов. Старые эритроциты утрачивают пластичность, из-за чего задерживаются в мелких сосудах селезенки и там же разрушаются.
Большая часть эритроцитов (до 80 %) имеет двояковогнутую сферическую форму. Остальные 20 % могут иметь другую: овальную, чашеобразную, сферическую простую, серповидную и пр. Нарушение формы связано с различными заболеваниями (анемией, дефицитом витамина B12, фолиевой кислоты, железа и др.).

Большую часть цитоплазмы эритроцита занимает гемоглобин, состоящий из белка и гемового железа, которое придает крови красный цвет. Небелковая часть представляет собой четыре молекулы гема с атомом Fe в каждой. Именно благодаря гемоглобину эритроцит способен переносить кислород и выводить углекислый газ. В легких атом железа связывается с молекулой кислорода, гемоглобин превращается в оксигемоглобин, придающий крови алый цвет. В тканях гемоглобин отдает кислород и присоединяет углекислый газ, превращаясь в карбогемоглобин, в результате кровь становится темной. В легких углекислый газ отделяется от гемоглобина и выводится легкими наружу, а поступивший кислород вновь связывается с железом.
Кроме гемоглобина, в цитоплазме эритроцита содержатся различные ферменты (фосфатаза, холинэстеразы, карбоангидраза и др.).
Оболочка эритроцита имеет достаточно простое строение, по сравнению с оболочками других клеток. Она представляет собой эластичную тонкую сетку, что обеспечивает быстрый газообмен.
На поверхности красных кровяных клеток находятся антигены разных видов, которые определяют резус-фактор и группу крови. Резус-фактор может быть положительным или отрицательным в зависимости от присутствия или отсутствия антигена Rh. Группа крови зависит от того, какие антигены находятся на мембране: 0, A, B (первая группа – 00, вторая – 0A, третья – 0B, четвертая – AB).
В крови здорового человека в небольших количествах могут быть недозрелые эритроциты, которые называются ретикулоцитами. Их количество увеличивается при значительной кровопотере, когда требуется возмещение красных клеток и костный мозг не успевает их производить, поэтому выпускает недозрелые, которые тем не менее способны выполнять функции эритроцитов по транспортировке кислорода.
Эритроциты, лейкоциты и тромбоциты
Эритроциты – это красные кровяные клетки, которые в организме выполняют дыхательную функцию: транспортируют кислород и углекислый газ по крови, а также регулируют содержание аминокислот и полипептидов в плазме (Б. И. Збарский). В 1 мм3 крови содержится 4-5,5 млн. эритроцитов. Они представляют собой двояковогнутый диск, окруженный мембраной. Местом образования эритроцитов является в основном костный мозг, а также селезенка и печень. Продолжительность жизни эритроцитов в циркулирующей крови составляет около 100 дней. Процесс созревания эритроцитов представляет собой сложный и сравнительно длительный процесс, когда из ядросодержащих клеток через стадии нормобластов, ретикулоцитов образуются эритроциты.
Из белков эритроцитов важнейшее значение принадлежит гемоглобину, содержание которого может доходить до 41%. Во всем количестве эритроцитов человека содержится примерно 800 г гемоглобина. В цельной крови количество гемоглобина составляет 13-18 г%. В настоящее время обнаружены различные формы гемоглобинов, отличающиеся по аминокислотному составу глобина – его белковой части. У эмбрионов человека на 7-12-й неделе обнаружен примитивный гемоглобин (НbР), который в дальнейшем замещается фетальным (HbF). Последний составляет 70-90% всего гемоглобина детей. У взрослого человека основную массу гемоглобина составляет гемоглобин A1 (HbA1).
При некоторых заболеваниях (серповидноклеточная анемия, талассемия) в крови больных обнаруживаются патологические формы гемоглобинов, получивших обозначения С, D, S и др. Эти заболевания относятся к наследственной патологии, в основе которой лежит нарушение процесса синтеза глобина.
При повреждении мембраны эритроцита под действием измененного осмотического давления, различных токсинов гемоглобин выходит в плазму. Такой процесс называется гемолизом. Уменьшение в крови гемоглобина приводит к развитию различных анемий. Снижение гемоглобина до 5% ведет к смерти.
В клинике имеет большое значение определение количества гемоглобина крови. Его концентрация у взрослых людей варьируете пределах 13-18 г%, у ребенка после рождения составляет 19,5 г%, ко второму месяцу снижается до 11,5 г%.и постепенно достигает уровня взрослых людей к 12 годам.
В клинике существуют различные методы определения гемоглобина, из которых наиболее распространенным является метод Сали, когда после прибавления к крови соляной кислоты гемоглобин превращается в солянокислый гематин коричневого цвета и по сравнению его окраски с окраской стандартного раствора определяют концентрацию гемоглобина. Другим показателем, применяемым для анализа красных кровяных телец, является цветной показатель. Последний позволяет получить представление о содержании гемоглобина в эритроцитах, на чем основана клиническая классификация анемий. Реакция оседания эритроцитов (РОЭ) является одной из самых важных и широко распространенных лабораторных методов исследования. Сущность ее состоит в том, что кровь, стабилизированная какими-либо веществами, оставленная в вертикальном сосуде, через некоторое время просветляется за счет оседания эритроцитов и других форменных элементов крови. Как установлено, скорость оседания эритроцитов у здоровых людей приблизительно одинакова и составляет 5-10 мм в час. При уменьшении показателя А/Г (острая стадия ревматизма, злокачественные новообразования, почечные заболевания, анемии) РОЭ ускорена. При сердечных и печеночных заболеваниях РОЭ замедлена
В клинической практике важное значение придают также методам исследования гемостаза, свертывания крови, ломкости капилляров
Лейкоциты. В 1 мм3 крови содержится 5-6 тыс. белых кровяных телец. Они подразделяются на ряд форм в зависимости от формы ядра и способа окраски.
Лейкоциты участвуют в процессах фагоцитоза – захватывания и переваривания инородных тел и бактерий. В местах воспаления всегда много лейкоцитов, которые в своей массе образуют гной.
Тромбоциты. Это безъядерные клетки. В 1 мм3 крови их содержится 200-300 тыс. Тромбоциты участвуют в процессах свертывания крови.
В чем разница между эритроцитами, лейкоцитами и тромбоцитами?
| Эритроциты | Эритроциты чаще называют эритроцитами. |
| Лейкоциты | Лейкоциты известны как белые кровяные тельца. |
| Тромбоциты | Тромбоциты обычно называют тромбоцитами. |
| Форма | |
| Эритроциты | Эритроциты двояковогнутой формы. |
| Лейкоциты | Лейкоциты неправильной формы. |
| Тромбоциты | Тромбоциты – это случайные фрагменты. |
| Количество на мм3 | |
| Эритроциты | Нормальное количество эритроцитов – 4-6 миллионов. |
| Лейкоциты | Количество лейкоцитов от 4000 до 11000. |
| Тромбоциты | Количество тромбоцитов 150 000 – 500 000. |
| Функция | |
| Эритроциты | Транспортировка кислорода – основная функция эритроцитов. |
| Лейкоциты | Иммунитет и защита – это функции лейкоцитов. |
| Тромбоциты | Свертывание крови – основная функция тромбоцитов. |
| Высокие условия | |
| Эритроциты | Полицитемия – это состояние, вызванное большим количеством эритроцитов. |
| Лейкоциты | Лейкоцитоз – это состояние, которое возникает из-за большого количества лейкоцитов. |
| Тромбоциты | Тромбоцитоз – это состояние, которое возникает из-за высокого уровня тромбоцитов. |
| Низкие условия | |
| Эритроциты | Анемия – это состояние, вызванное низким уровнем эритроцитов. |
| Лейкоциты | Лейкопения – это состояние, вызванное низким уровнем лейкоцитов. |
| Тромбоциты | Тромбоцитопения – это состояние, вызванное низким уровнем тромбоцитов. |
| Сопутствующие заболевания | |
| Эритроциты | Серповидно-клеточная анемия – это заболевание, вызванное аномальными эритроцитами. |
| Лейкоциты | Лейкемия – это заболевание, вызванное аномально повышенной выработкой лейкоцитов. |
| Тромбоциты | Гемофилия – это заболевание, вызванное меньшим количеством тромбоцитов. |
Резюме – Эритроциты vs Лейкоциты против тромбоцитов
Эритроциты более известны как красные кровяные тельца, которые участвуют в транспортировке газов, в основном кислорода, к различным клеткам и тканям, присутствующим в организме. Эритроцит – это небольшая клетка крови двояковогнутой формы. Когда он созревает, он не содержит ядра. Эритроциты образуются и развиваются в костном мозге из гемоцитобластов. Продолжительность жизни нормального эритроцита 100-120 дней. Он разрушен в селезенке. Лейкоциты известны как белые кровяные тельца. Они считаются основными клетками иммунной системы организма. Нормальное количество лейкоцитов у здорового человека составляет 4000-11000 клеток на микролитр крови. Лейкоциты состоят из ядра. Тромбоциты обычно называют тромбоцитами. Это компонент, присутствующий в крови, который в основном участвует в процессе свертывания крови. Тромбоциты не считаются клетками. Они являются фрагментами цитоплазмы и не содержат ядра. В этом разница между эритроцитами, лейкоцитами и тромбоцитами.
Скачать PDF-версию эритроцитов против лейкоцитов против тромбоцитов
Вы можете скачать PDF-версию этой статьи и использовать ее в автономных целях в соответствии с примечанием к цитированию. Пожалуйста, скачайте PDF-версию здесь. Разница между эритроцитами, лейкоцитами и тромбоцитами.







![Эритроциты, лейкоциты и тромбоциты [1974 ермолаев м.в. - биологическая химия]](https://otlichaet.com/wp-content/uploads/6/5/8/658c1f76b564818e2ab62e9d38764837.jpeg)














![Эритроциты и лейкоциты [1982 цузмер а.м., петришина о.л. - человек. анатомия, физиология и гигиена]](https://otlichaet.com/wp-content/uploads/d/2/3/d2387d9d3fa5e620a1711ca9f335b04e.jpeg)







